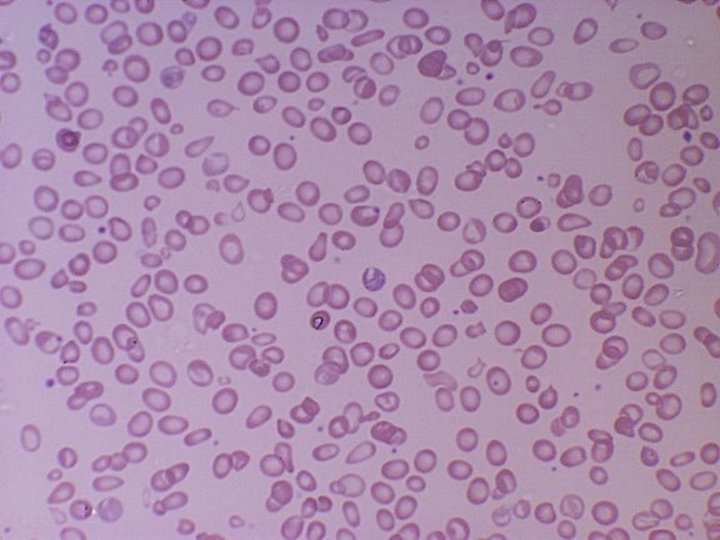
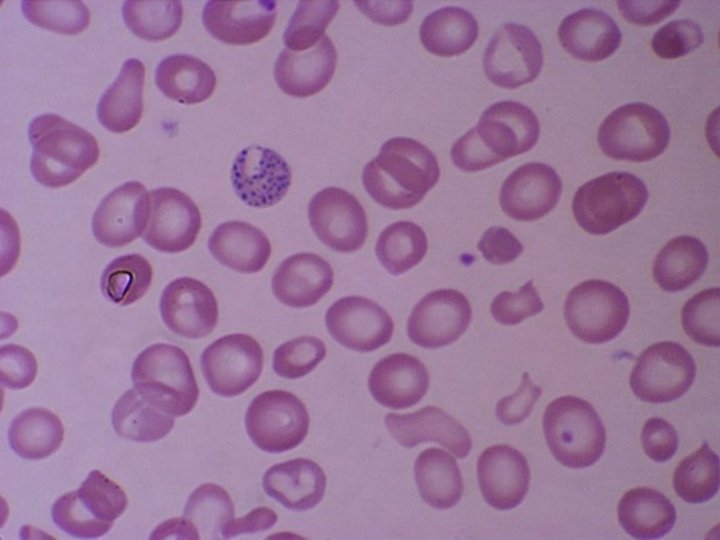

Hematologia Casos Clnicos Antonio de Almeida Caso 1

- Slides: 39
Hematologia Casos Clínicos Antonio de Almeida
Caso 1 Doente de 17 anos, sexo masculino, estudante Referenciado por odinofagia, febre e fadiga há uma semana Sem resposta à antibioterapia Exame Objectivo: Pálido, sub-ictérico Amigdalite Adenopatias superficiais generalizadas Ponta de baço palpável
Hemograma Hb – 8, 7 g/dl Leucócitos – 8100/ l Plaquetas - 168 000 / l VGM – 96 fl (N - 900 / l, L - 6300 / l) Reticulócitos 216 x 109/L Esfregaço: Policromasia, linfócitos activados Teste de Coombs: + (complemento) Outros exames ?
Caso 2 Doente de 73 anos, sexo masculino, viuvo, reformado Referenciado por astenia acentuada e progressiva nos últimos 6 meses Anemia e adenopatias cervicais e axilares Hemograma: Hb – 7 g/dl VGM – 112 fl Leucócitos - 3200 / l Plaquetas – 80 000 / l
Biópsia ganglionar Linfoma não Hodgkin do centro folicular (poliadenoptias) Medulograma e Biópsia Óssea Sugestivos de mielodisplasia Sem infiltração por linfoma Outros exames a pedir
Anemia megaloblástica • Deficiência de Vitamina B 12 ou folato • Necessárias para replicação DNA • B 12: – – – Perniciosa Íleo terminal Má absorção Vegetarianismo Diphalotropum latum • Folato: – Má nutrição – Má absorção – Aumento de consumo
Caso 3 • 70 anos • Sexo masculino • Astenia – Hb 5. 9 VGM 103 – Leuc 3, 5 – plq 37, 000
Caso 3 • • B 12 / folato normais Nega consumo de álcool / drogas Função hepática normal Função tiróideia normal • Mielograma:
hipolobulacao
micromegas
Displasia eritroide
Sider anel
SMD • Doença clonal • Incidência: 4 – 10 em 105 população 30 em 105 >70 anos • Citopénias / macrocitose • Progressão para LMA • Risco: • Blastos • Citopenias • Citogenética
Anomalias cromossómicas mais frequentes em SMD Pacientes (%) n = 2, 072 OS = overall survival. Haase D, et al. Blood. 2005. 106: 232 a. Prognóstico bom (OS ≥ 24 months) Prognóstico intermédio (OS 12– 24 months) Mau prognóstico (OS ≤ 12 months) Prognóstico intermédio a mau
IPSS: Sobrevivência e progressão para LMA % 100 Sobrevivência B 90 80 80 70 70 60 60 50 50 40 Low 30 Int-1 20 Int-2 10 High 0 0 1 2 3 4 5 6 7 8 9101112131415161718 anos Greenberg P, et al. Blood. 1997. 89: 2079– 88. 5. 7 3. 5 1. 2 0. 4 LMA 0. 2 100 90 % A 1. 1 3. 3 40 30 9. 4 20 10 0 0 1 2 3 4 5 6 7 8 9101112131415161718 anos
Factores de risco • Quimioterapia – Agentes alquilantes - Ch 7 – Inibidores topoisomerase II – 11 q 23 • Benzeno – Tabaco – Ocupacional • Radiação • Tinta cabelo • Risco familiar
Diagnóstico diferencial de anemia macrocítica • Megaloblástica – B 12 – Folato • • • Hipotiroidismo Gravidez Reticulocitose Álcool / disfunção hepática SMD
Caso 4 5 anos, sexo feminino Anaemia e esplenomegalia Mãe e avó materna com “anemia” E/O Pálida e ictérica esplenomegalia 2 cm Hb 8. 4 g/dl VGM 73. 7 fl, VGH 23. 7 pg Reticulocitos 55. 2 (1. 57%) Ferritina 52 Saturação transferrina 35% Hb. A 2 3. 7% Hb. F 16. 7% Bilirubina 56µmol/l (2)
Anemia microcítica • Ferropénica – Hemorragia: menstrual, GI – Má nutrição – Má absorção – Ferritina, capacidade total fixação ferro, saturação transferrina • Hemoglobinopatias – Talasémia: α e β – Hb. A 2>3. 5%
Hemoglobinopatias
Hemoglobinopatias • Recessiva • 2 genes β, 4 genes α • Quantitativos: talasémias • Qualitativos: drepanocitose, alta afinidade, instável
-Talasémia Minor, intermédia, major • Minor: heterozigoto • Intermédia: Homozigoto ++/ ++ ou ++/ + co-existência de -thalassaemia persistência hereditária de Hb. F (HPFH) mutação promotor 5’ gene globina Heterozigotia composta - talasémia e HPFH ou - talasémia Heterozigotia - talasémia com ou -talasémia dominanter • Major: homozigoto, dependente de tranfusões
Caso 5 • 63 anos, sexo feminino • Astenia • Hb 9, 0, Leuc 328, plq 540 • Mielémia, bsaofilia • Esplenomegalia 10 cm
Imatinib
Caso 5 • Hidroxiureia para citoredução • Inicia Imatinib • 3 meses : resposta hematológica completa • 6 meses: resposta citogenética completa • PCR: 0. 01% BCR-ABL
Sobrevivência aos 6 anos: 84%
1012 1011 1010 109 100% Ph+ 100% Resposta Hematológica Completa 10% Resposta citogenética completa 1% 0. 1% Resposta molecular major 108 0. 01% 0, 005% 107 0. 001% Resposta molecular completa 106 0. 0001 A percentagem de BCR-ABL reflete o número de células leucémicas % BCR-ABL% Número de células leucémicas Monitorização molecular
Resistência ao Imatinib
Outros mecanismos de resistência • Duplicação de Ph • Novas alterações oncogénicas • Redução de Imatinib intracelular – MRD – extrusão activa – Incorporação reduzida
Novos inibidores do BCR-ABL • Dasatinib: – Inibe BCR-ABL e Src – 300 x mais potente que Imatinib – Activo contra todas as mutações de BCRABL menos T 315 I • Nilotinib: – 20 x mais potente que Imatinib – Activo contra todas as mutações de BCRABL menos T 315 I